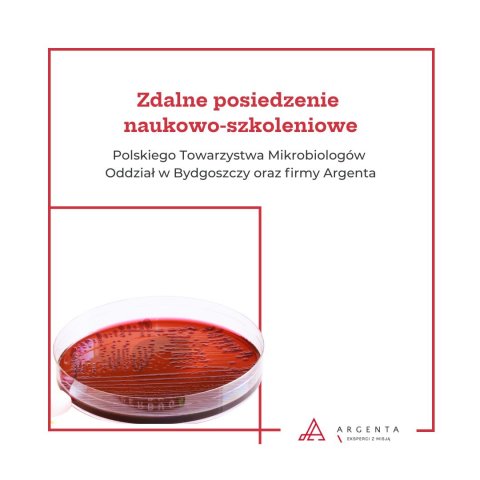
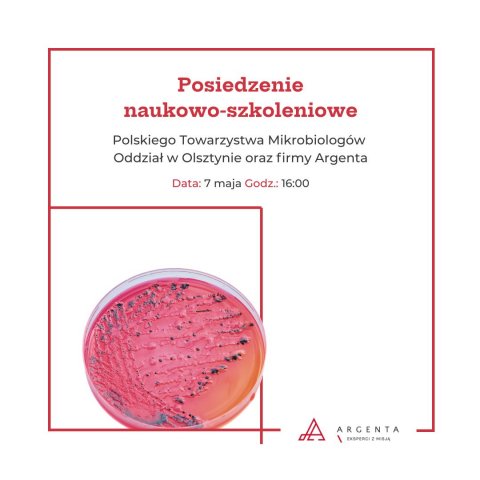
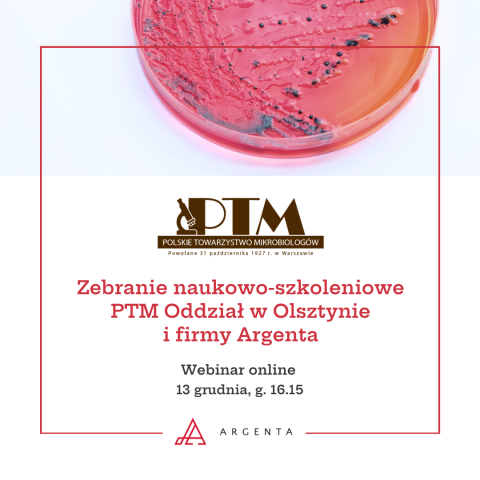
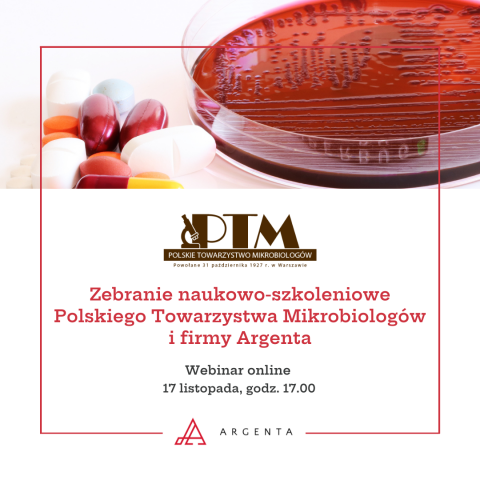
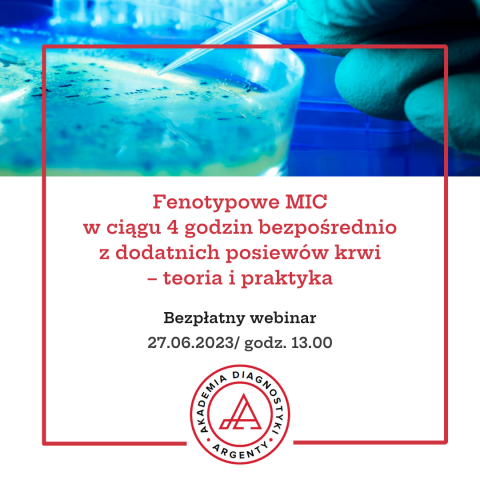
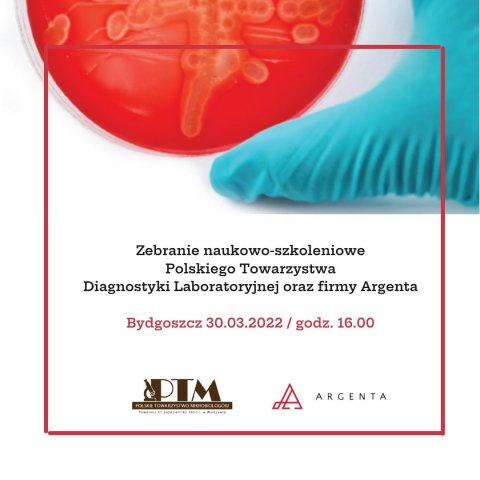

Webinar edukacyjny Szkoły Diagnostyki Weterynaryjnej Argenty „Diagnostyka u zwierząt – od teorii do praktyki klinicznej”
Argenta ma przyjemność zaprosić Państwa na bezpłatny webinar on-line pt. „Diagnostyka u zwierząt – od teorii do praktyki klinicznej”, organizowany w ramach Szkoły Diagnostyki Weterynaryjnej Argenty.
Wydarzenie odbędzie się 27 maja br. (środa), o g. 18:00.
Rejestracja na webinar online: link
Podczas spotkania przyjrzymy się współczesnej diagnostyce weterynaryjnej oraz jej roli w codziennej praktyce klinicznej.
Porozmawiamy o:
- diagnostyce laboratoryjnej układu hemostazy osoczowej,
- wykorzystaniu diagnostyki w codziennej praktyce weterynaryjnej - wskazaniach do badań oraz interpretacji wyników.
Program spotkania:
18:00-18:05 – Powitanie uczestników
18:05-18:45 – Diagnostyka laboratoryjna układu hemostazy osoczowej
dr Andrzej Milczak, Katedra Chorób Wewnętrznych, Wydział Medycyny Weterynaryjnej, Uniwersytet Przyrodniczy w Lublinie
18:45-19:15 – Diagnostyka w praktyce gabinetu weterynaryjnego- kiedy badać i jak interpretować wyniki?
Lek. wet. Urszula Taraska, Lecznica dla psów i kotów w Sierakowie
19:15-19:30 – Sesja Q&A
19:30-19:35 – Zakończenie spotkania
Zapraszamy do udziału osoby zainteresowane diagnostyką weterynaryjną, interpretacją wyników badań oraz praktycznym wykorzystaniem diagnostyki w codziennej pracy gabinetu weterynaryjnego.
Zapraszamy do rejestracji!

Zdalne posiedzenie naukowo-szkoleniowe Polskiego Towarzystwa Mikrobiologów oddział w Gdańsku
W imieniu Polskiego Towarzystwa Mikrobiologów Oddział w Gdańsku oraz firmy Argenta Sp. z o.o. serdecznie zapraszamy na zdalne posiedzenie naukowo-szkoleniowe, które odbędzie się 26 maja 2026 (wtorek) od godz. 16:00.
Rejestracja na webinar online: link
Harmonogram spotkania:
16:00–16:10 Powitanie i rozpoczęcie spotkania
– prof. dr hab. Katarzyna Garbacz, Gdański Uniwersytet Medyczny, Wydział Lekarski, Katedra Mikrobiologii, Zakład Mikrobiologii Jamy Ustnej, Przewodnicząca Oddziału Terenowego PTM w Gdańsku
16:10–16:30 Obraz kliniczny, mikrobiologiczny i immunologiczny nosowej części gardła u dzieci z astmą oskrzelową kwalifikowanych do adenotomii
– Lek. med. Katarzyna Żyżyńska, specjalista otolaryngologii, Kliniczny Oddział Otolaryngologii Akademii Nauk Stosowanych Medycznych i Społecznych w Elblągu, Szpital im. Mikołaja Kopernika w Gdańsku
16:30–16:50 Profil mikrobiologiczny pacjentów z przewlekłym zapaleniem migdałków podniebiennych kwalifikowanych do tonsillektomii
– Lek. med. Agnieszka Kasprzyk-Tryk, specjalista otolaryngologii, Kliniczny Oddział Otolaryngologii Akademii Nauk Stosowanych Medycznych i Społecznych w Elblągu, Szpital im. Mikołaja Kopernika w Gdańsk
16:50–17:10 Wielolekooporne bakterie w zakażeniach pozaszpitalnych u pacjentów onkohematologicznych – podejście One Health
– Dr n. med. Bartosz Rybak, specjalista mikrobiologii, Katedra i Zakład Mikrobiologii Farmaceutycznej Gdański Uniwersytet Medyczny, Laboratorium Mikrobiologii Klinicznej Uniwersyteckie Centrum Kliniczne w Gdańsku
17:10–17:25 Nowoczesne rozwiązania diagnostyczne
– prezentacja firmowa Argenta Sp. z o.o.
17:25–17:45 Sesja Q&A
17:45 Podsumowanie i zakończenie spotkania
– prof. dr hab. Katarzyna Garbacz, Przewodnicząca Oddziału Terenowego PTM w Gdańsku
Za udział w zdalnym posiedzeniu zostaną przyznane 2 punkty edukacyjne.

Webinar edukacyjny Argenta Experience Lab pt. „Alergeny pod lupą- nadzór nad alergenami w produkcji żywności oraz przegląd testów ELISA i LFT”
Szanowni Państwo,
serdecznie za praszamy do wzięcia udziału w webinarze edukacyjnym pt. „Alergeny pod lupą - nadzór nad alergenami w produkcji żywności oraz przegląd testów ELISA i LFT” z cyklu Argenta Experience Lab, który odbędzie się w 21 maja (czwartek) od godz. 13:00.
Rejestracja na webinar - link
O czym będziemy rozmawiać?
Webinar ma na celu uaktualnienie lub poszerzenie wiedzy z zakresu alergenów oraz nadzoru nad alergenami w zakładzie produkcyjnym. W trakcie wydarzenia będziemy poruszać zagadnienia związane z:
- alergenami w przemyśle spożywczym - zagrożenia i aspekty prawne;
- Prawem Unii Europejskiej dotyczącym alergenów w żywności (zidentyfikowanie źródeł, analiza zagrożeń).
Program spotkania:
13:00-13:05 – Powitanie uczestników
Magdalena Grabowska, Specjalista ds. strategii i rozwoju marki, Argenta Sp. z o.o.
13:05-13:30 – Alergeny w zakładzie produkcyjnym – gdzie teoria spotyka praktykę i pojawiają się problemy
Ewa Brzezicka, Head of Laboratory, Quality Control/Laboratory, Mowi Poland S.A.
13:30-13:55 – Spojrzenie makro na rynek alergenów, okiem dostawcy testów diagnostycznych. Okazja biznesowa dla podmiotów z szeroką ofertą
Daniel Dolata, Regional Sales Manager, który przedstawi ofertę rozwiązań Gold Standard Diagnostics
13:55-14:10 – Sesja Q&A
14:10-14:15 – Zakończenie spotkania
Webinar skierowany jest do osób zainteresowanych tematyką: alergenów w żywności, nadzorem nad alergenami w zakładach produkcyjnych, bezpieczeństwem żywności, kontrolą jakości oraz badaniami laboratoryjnymi.
Zapraszamy do rejestracji!

Zdalne posiedzenie naukowo-szkoleniowe Polskiego Towarzystwa Mikrobiologów oddział w Lublinie
Szanowni Państwo,
w imieniu Polskiego Towarzystwa Mikrobiologów – Oddział w Lublinie oraz firmy Argenta Sp. z o.o. serdecznie zapraszamy do udziału w zdalnym posiedzeniu naukowo‑szkoleniowym, poświęconym zagadnieniom związanym z bakteriami Legionella.
Rejestracja na webinar: link
Data: 19 maja 2026 r.
Godzina: 13:30–14:55
Forma: webinar online
Punkty edukacyjne: 2 punkty
Program spotkania:
13:30–13:40 – Powitanie i rozpoczęcie spotkania
dr hab. Jolanta Jaroszuk‑Ściseł, prof. UMCS
13:40–14:00 – Molekularne mechanizmy interakcji Legionella pneumophila z gospodarzem
dr hab. Marta Palusińska‑Szysz, prof. UMCS
14:00–14:20 – Nowoczesne rozwiązania do diagnostyki Legionella spp.
Prezentacja firmowa Argenta Sp. z o.o.
14:20–14:40 – Rola plazmidów w adaptacji i wirulencji bakterii Legionella
dr Piotr Koper, UMCS
14:40–14:55 – Sesja Q&A i podsumowanie
Zapraszamy wszystkich zainteresowanych mikrobiologią, diagnostyką laboratoryjną oraz nowoczesnymi metodami identyfikacji patogenów.

Webinar online: Leczenie inwazyjnych zakażeń grzybiczych
Szanowni Państwo,
Argenta oraz Thermo Fisher Scientific mają przyjemność zaprosić Państwa na bezpłatny webinar online, poświęcony aktualnym wyzwaniom diagnostycznym i terapeutycznym w zakażeniach grzybiczych.
Rejestracja na webinar: link
Data: 12 maja br., g. 17.00
Harmonogram spotkania:
17.00-17.05 – Powitanie oraz rozpoczęcie wydarzenia
17.05-17.25 – Bezpośrednia identyfikacja Candida auris na pożywce Thermo Scientific Brilliance Candida 2 Agar
– Ewa Kaniuk, Technical Sales Specialist, Thermo Fisher Scientific
17.25-18.10 – Trudności diagnostyczne i terapeutyczne w leczeniu inwazyjnych zakażen grzybiczych
– dr n. med. Beata Sulik-Tyszka, Zakład Mikrobiologii Klinicznej NIO-PIB, Warszawa
18.10-18.25 – Pytania od uczestników i zakończenie wydarzenia
Webinar skierowany jest do mikrobiologów, diagnostów laboratoryjnych, lekarzy oraz wszystkich specjalistów zainteresowanych nowoczesnymi metodami diagnostyki i leczenia zakażeń grzybiczych.
Serdecznie zachęcamy do udziału!

Webinar online: V edycja Akademii Bezpieczeństwa Żywności „Listeria pod szczególnym nadzorem. Nowe wymagania i praktyczne konsekwencje dla producentów żywności”
Szanowni Państwo,
serdecznie zapraszamy do udziału w webinarze online „Listeria pod szczególnym nadzorem. Nowe wymagania i praktyczne konsekwencje dla producentów żywności” w ramach V edycji Akademii Bezpieczeństwa Żywności.
Zmiany w otoczeniu regulacyjnym nie są dziś jedynie formalnością. W przypadku Listeria monocytogenes oznaczają one realne konsekwencje dla producentów żywności, laboratoriów i zespołów odpowiedzialnych za bezpieczeństwo produkcji.
Podczas najbliższej edycji Akademii Bezpieczeństwa Żywności Argenty skupimy się na zagadnieniach związanych z wdrożeniem Rozporządzenia Komisji Europejskiej dotyczącego limitów dla Listeria monocytogenes oraz na tym, jak nowe wymagania przekładają się na codzienną praktykę zakładów produkcyjnych i laboratoriów. W programie webinaru zawarliśmy trzy perspektywy: regulacyjną, analityczną i technologiczną.
Webinar odbędzie się 28 kwietnia (wtorek) o g. 13:00.
Rejestracja na webinar - link
Program wydarzenia:
13:00-13:15 - Rozpoczęcie i moderacja spotkania - Maciej Słomkowski, Business Development Manager, Argenta
13:15-13:40 - Listeria pod specjalnym nadzorem – jak nowelizacja Rozporządzenia 2073/2005 zmienia ciężar dowodu w Twojej firmie - dr Ewelina Kijewska, GBA Polska Sp. z o.o.
13:40-14:05 - Optymalizacja jakościowo-kosztowa w wykrywaniu bakterii z rodzaju Listeria spp. - dr Piotr Gutry, Field Application Specialist, Thermo Fisher Scientific
14:05-14:30 - Zarządzanie niezgodnością Listeria monocytogenes w świetle zmiany Rozp. (WE) 2073/2005 - dr inż. Anna Bugajewska, Ekspert Mérieux NutriSciences
14:30-14:45 - Metody wykrywania Listeria monocytogenes w żywności i próbkach środowiskowych - Joanna Szwiec, Specjalista ds. Produktu, Argenta
Zapraszamy do udziału osoby odpowiedzialne za jakość, bezpieczeństwo żywności, badania laboratoryjne, mikrobiologię oraz nadzór nad procesami produkcyjnymi.

Szkolenie stacjonarne „Szybkie metody wykrywania mikroorganizmów z powierzchni - metody luminometryczne z wykorzystaniem systemu EnSURE Touch"
Szanowni Państwo,
serdecznie zapraszamy do wzięcia udziału w szkoleniu pt. „Szybkie metody wykrywania mikroorganizmów z powierzchni - metody luminometryczne z wykorzystaniem systemu EnSURE Touch", które odbędzie się w siedzibie firmy Argenta przy ul. Człuchowskiej 6 w Poznaniu, 17 marca br. od g. 10.00.
Rejestracja - Zapisz się na szkolenie tutaj
W trakcie szkolenia omówimy:
- proces pomiaru pozostałości ATP;
- analizę danych i tworzenie trendów z wykorzystaniem platformy SureTrend®.
Wydarzenie poprowadzą dr Sebastian Antoń, Regional Sales Leader, firma Hygiena oraz Grzegorz Drążek, Przedstawiciel Regionalny - Mikrobiologia Przemysłowa, firma Argenta.
Program spotkania:
10:00-10:15 - Powitanie uczestników
10:15-11:00 - System EnSURE Touch - pomiar pozostałości ATP, analiza danych i tworzenie trendów z wykorzystaniem platformy SureTrend Cloud - część merytoryczna
11:00-13:00 - Warsztaty laboratoryjne – wykonywanie pomiarów ATP, odczyt i interpretacja wyników
13:00-13:45 - Lunch
13:45-14:00 - Podsumowanie spotkania, dyskusja
Formularz rejestracyjny
Termin przyjmowania zapisów: do wyczerpania miejsc
Udział drugiego przedstawiciela tej samej firmy gratis

Webinar online „Luminometria w praktyce: sprawdzone sposoby na efektywny monitoring higieny produkcji"
Szanowni Państwo,
serdecznie zapraszamy do wzięcia udziału w webinarze pt. „Luminometria w praktyce: sprawdzone sposoby na efektywny monitoring higieny produkcji", który odbędzie się 12 lutego (czwartek), o g. 13:30.
Rejestracja - Zapisz się na webinar tutaj
W trakcie webinaru omówimy:
- rolę kontroli higieny w systemach jakości i bezpieczeństwa;
- dlaczego szybka weryfikacja czystości jest kluczowa w codziennej praktyce;
- wykrywanie mikroorganizmów z wykorzystaniem systemu EnSURE Touch;
- platformę SureTrend® – analiza danych i tworzenie trendów, praktyczne przykłady.
Program spotkania:
13:30-13:35 – Rozpoczęcie spotkania; Magdalena Grabowska, Specjalista ds. strategii i rozwoju marki, Argenta Sp. z o.o.
13:35-13:50 – Rola kontroli higieny w systemach jakości i bezpieczeństwa; Joanna Szwiec, Specjalista ds. Produktu, Argenta Sp. z o.o.
13:50-14:15 – Szybkie metody wykrywania mikroorganizmów z powierzchni – metody luminometryczne z wykorzystaniem systemu EnSURE Touch; Sebastian Antoń, Regional Sales Leader, Hygiena
14:15-14:25 – Sesja Q&A
14:25-14:30 – Zakończenie wydarzenia; Magdalena Grabowska
Prelegenci:
Joanna Szwiec – Specjalista ds. Produktu w firmie Argenta, absolwentka biologii eksperymentalnej i molekularnej na Wydziale Biologii UAM w Poznaniu. Swoje doświadczenie zawodowe zdobywała jako mikrobiolog w akredytowanych laboratoriach zajmujących się badaniami żywności, pasz, środowiska oraz analizą mikrobiologiczną wody pitnej i basenowej. W pracy łączy wiedzę naukową z praktycznym podejściem do wdrażania nowoczesnych rozwiązań laboratoryjnych.
dr Sebastian Antoń – Regional Sales Leader w firmie Hygiena, absolwent Uniwersytetu Przyrodniczego w Lublinie, Uniwersytetu Jagiellońskiego w Krakowie oraz Lubelskiej Akademii WSEI. Posiada ponad 10-letnie doświadczenie w branży Food Safety, które wykorzystuje we wdrażaniu i walidacji metod analitycznych w laboratoriach badających żywność. Specjalizuje się w mikrobiologicznej analizie żywności – zarówno metodami referencyjnymi, jak i alternatywnymi – oraz w kontroli stanu higienicznego w warunkach produkcyjnych.

Automatyzacja w analizie ilościowej EasySpiral Dilute i SCAN 3000 AI od Interscience
Materiały szkoleniowe:
Metoda Spiral® w wykonywaniu rozcieńczeń i posiewów (Pobierz materiały)
oraz precyzyjne liczenie kolonii oparte na sztucznej inteligencji (Pobierz materiały).

Automatyzacja w analizie ilościowej EasySpiral Dilute i SCAN 3000 AI od Interscience
Szanowni Państwo,
zapraszamy do udziału w stacjonarnym szkoleniu teoretyczno-praktycznym pt. „Automatyzacja w analizie ilościowej EasySpiral Dilute i SCAN 3000 AI od Interscience”.
Szkolenie poprowadzą Joanna Szwiec, Specjalista ds. Produktu, oraz Jacek Charliński Project & Key Account Manager z firmy Argenta. Spotkanie odbędzie się w siedzibie firmy przy ul. Człuchowskiej 6 w Poznaniu, 29 stycznia br. (czwartek) od g. 10.00.
Program spotkania:
10:00-10:15 – Powitanie uczestników
10:15-11:00 – Metoda Spiral® w wykonywaniu rozcieńczeń i posiewów oraz precyzyjne liczenie kolonii oparte na sztucznej inteligencji – część merytoryczna
11:00-13:00 – Warsztaty laboratoryjne –wykonywanie rozcieńczeń i posiewów z wykorzystaniem urządzenia EasySpiral Dilute, obsługa oraz testowanie działania Scan 3000 AI na przygotowanych płytkach z posiewami – część praktyczna
13:00-13:45 – Lunch
13:45-14:00 – Podsumowanie spotkania, dyskusja
Zapisy przyjmujemy do 23 stycznia br. lub do wyczerpania miejsc.
Udział drugiego i kolejnych przedstawicieli tej samej firmy płatny 250 zł netto od osoby.
Zachęcamy do rejestracji!

Zdalne posiedzenie naukowo-szkoleniowe Polskiego Towarzystwa Mikrobiologów Oddział w Bydgoszczy
Materiały do pobrania:
Kontaminacja mikrobiologiczna wody procesowej w przemyśle owocowo-warzywnym, czyli co „mieszka” na pomidorach - mgr Piotr Kanarek, Katedra Mikrobiologii i Ekologii Roślin Wydział Rolnictwa i Biotechnologii Politechnika Bydgoska im. Jana i Jędrzeja Śniadeckich
Pobierz
Molekularne podstawy oporności na karbapenemy i kolistynę, czyli w jaki sposób Acinetobacter baumannii wymyka się „wymiarowi antybiotykowej sprawiedliwości” mgr Dagmara Depka-Radzikowska, Katedra Mikrobiologii Collegium Medicum im. Ludwika Rydygiera w Bydgoszczy Uniwersytet Mikołaja Kopernika w Toruniu i Zakład Mikrobiologii Klinicznej Szpital Uniwersytecki Nr 1 im. dr. A. Jurasza w Bydgoszczy
Pobierz
Synergizm jako koncepcja antybiotykoterapii zakażeń wywołanych przez szczepy wielolekooporne, czyli jeden za wszystkich, wszyscy na jednego – dr Anna Oczkowska, Wielospecjalistyczny Szpital Miejski im. J. Strusia w Poznaniu
Pobierz
Opcje terapeutyczne w stosunku do bakterii najczęściej izolowanych z moczu, czyli antybiotykowe Uniwersum w ZUM mgr Agata Chalasiewicz, Laboratorium Mikrobiologiczne Uniwersytecki Szpital Kliniczny we Wrocławiu
Pobierz
Nowoczesne podejście do oznaczania lekowrażliwości. dRAST i Sensititre ARIS HiQ – zautomatyzowane rozwiązania dla szybkiej i precyzyjnej diagnostyki dr Dawid Kościelniak, Specjalista ds. Aplikacji Mikrobiologia, Argenta Sp. z o.o.
Pobierz
Zdalne posiedzenie naukowo-szkoleniowe Polskiego Towarzystwa Mikrobiologów Oddział w Bydgoszczy
Szanowni Państwo,
Europejski Dzień Wiedzy o Antybiotykach przypadający 18 listopada br. to okazja by w gronie ekspertów omówić najświeższe dane, mechanizmy oporności oraz nowoczesne narzędzia diagnostyczne, które wspierają racjonalną antybiotykoterapię i skuteczną kontrolę zakażeń.
W imieniu Polskiego Towarzystwa Mikrobiologów Odział w Bydgoszczy oraz firmy Argenta serdecznie zapraszamy na zdalne posiedzenie naukowo-szkoleniowe, które odbędzie się 18 listopada (wtorek), o godz. 16.00.
Harmonogram spotkania:
16:00 – 16:05 Powitanie i rozpoczęcie spotkania – dr n. med. Agnieszka Mikucka, Przewodnicząca PTM Oddział w Bydgoszczy i dr n. med. Tomasz Bogiel, Sekretarz PTM Oddział w Bydgoszczy
16:05 – 16:25 Kontaminacja mikrobiologiczna wody procesowej w przemyśle owocowo-warzywnym, czyli co „mieszka” na pomidorach – mgr Piotr Kanarek, Katedra Mikrobiologii i Ekologii Roślin Wydział Rolnictwa i Biotechnologii Politechnika Bydgoska im. Jana i Jędrzeja Śniadeckich
16:25 – 16:50 Molekularne podstawy oporności na karbapenemy i kolistynę, czyli w jaki sposób Acinetobacter baumannii wymyka się „wymiarowi antybiotykowej sprawiedliwości” – mgr Dagmara Depka-Radzikowska, Katedra Mikrobiologii Collegium Medicum im. Ludwika Rydygiera w Bydgoszczy Uniwersytet Mikołaja Kopernika w Toruniu i Zakład Mikrobiologii Klinicznej Szpital Uniwersytecki Nr 1 im. dr. A. Jurasza w Bydgoszczy
16:50 – 17:15 Synergizm jako koncepcja antybiotykoterapii zakażeń wywołanych przez szczepy wielolekooporne, czyli jeden za wszystkich, wszyscy na jednego – dr Anna Oczkowska, Wielospecjalistyczny Szpital Miejski im. J. Strusia w Poznaniu
17:15 – 17:40 Opcje terapeutyczne w stosunku do bakterii najczęściej izolowanych z moczu, czyli antybiotykowe Uniwersum w ZUM – mgr Agata Chalasiewicz, Laboratorium Mikrobiologiczne Uniwersytecki Szpital Kliniczny we Wrocławiu
17:40 – 18:55 Nowoczesne podejście do oznaczania lekowrażliwości. dRAST i Sensititre ARIS HiQ – zautomatyzowane rozwiązania dla szybkiej i precyzyjnej diagnostyki – dr Dawid Kościelniak, Specjalista ds. Aplikacji Mikrobiologia, Argenta Sp. z o.o.
17:55 – 18:10 Sesja Q&A
18:10 Podsumowanie i zakończenie spotkania – dr n. med. Agnieszka Mikucka, Przewodnicząca PTM Oddział w Bydgoszczy i dr n. med. Tomasz Bogiel, Sekretarz PTM Oddział w Bydgoszczy

Akademia Diagnostyki Argenty
Materiały do pobrania:
POCcelerator – narzędzie IT do zarządzania analizatorami POCT
- Marcin Gajda, Product Specialist and Business Developer, Siemens Healthcare Sp. z o.o.
Pobierz
Portfolio analizatorów POCT i ich zastosowanie w ofercie Argenta
- Dominik Latoszek – Ambasador Projektu POCT, Dział Klinika Argenta Sp. z o.o.
Pobierz

Akademia Diagnostyki Argenty
Szanowni Państwo,
serdecznie zapraszamy na webinar Akademii Diagnostyki Argenty, poświęcony praktycznym aspektom zarządzania analizatorami POCT oraz możliwościom, jakie oferują nowoczesne rozwiązania technologiczne w diagnostyce przyłóżkowej. Wydarzenie odbędzie się 6 listopada (czwartek), o g. 16:30.
Harmonogram spotkania:
16.30-16.35 - Powitanie oraz rozpoczęcie wydarzenia
16.35-17.05 - POCcelerator- narzędzie IT do zarządzania analizatorami POCT
- Marcin Gajda, Product Specialist and Business Developer, Siemens Healthcare Sp. z o.o.
17.05-17.20 - Portfolio analizatorów POCT i ich zastosowanie w ofercie Argenta
- Dominik Latoszek - Ambasador Projektu POCT, Dział Klinika, Argenta Sp. z o.o.
17.20-17.30 - Pytania od uczestników i zakończenie wydarzenia
Zachęcamy do rejestracji i udziału w wydarzeniu!

Akademia Diagnostyki Argenty
Materiały do pobrania:
Błędy w POCT - jak im zapobiegać
- Arkadiusz Wnuk - Koordynator POCT w Szpitalu Uniwersyteckim w Krakowie
Pobierz
Portfolio analizatorów POCT i ich zastosowanie w ofercie Argenta
- Dominik Latoszek - Ambasador Projektu POCT, Dział Klinika Argenta Sp. z o.o.
Pobierz

Akademia Diagnostyki Argenty
Szanowni Państwo,
serdecznie zapraszamy na webinar Akademii Diagnostyki Argenty, poświęcony praktycznym aspektom zapewnienia jakości i bezpieczeństwa badań przyłóżkowych (POCT) w codziennej pracy placówek medycznych, które odbędzie się 23 października (czwartek), o g. 16:30.
Harmonogram spotkania:
16:30-16:35 - Powitanie oraz rozpoczęcie wydarzenia
16:35-17:20 - Błędy w POCT - jak im zapobiegać
- Arkadiusz Wnuk - Koordynator POCT w Szpitalu Uniwersyteckim w Krakowie
17:20-17:35 - Portfolio analizatorów POCT i ich zastosowanie w ofercie Argenta
- Dominik Latoszek - Key Account Manager ds. Rozwoju Rynku Klinicznego, Dział Klinika Argenta Sp. z o.o.
17:35-17:45 - Pytania od uczestników i zakończenie wydarzenia
Zachęcamy do rejestracji i udziału w wydarzeniu!

Zdalne posiedzenie naukowo-szkoleniowe Polskiego Towarzystwa Diagnostyki Laboratoryjnej Oddział w Bydgoszczy
Materiały do pobrania:
Biochemiczne aspekty działania radiofarmaceutyków
– dr Jolanta Czuczejko, Zakład Medycyny Nuklearnej Centrum Onkologii w Bydgoszczy oraz Katedra Psychiatrii CM UMK
Pobierz
Wykorzystanie nowoczesnych metod w diagnostyce immunochemicznej na przykładzie celiakii. Najnowsze rozwiązanie firmy Argenta
– Agata Stolarczyk, Project Manager, Biochemia i Immunochemia, Argenta Sp. z o.o.
Pobierz

Zdalne posiedzenie naukowo-szkoleniowe Polskiego Towarzystwa Diagnostyki Laboratoryjnej Oddział w Bydgoszczy
Szanowni Państwo,
w imieniu Polskiego Towarzystwa Diagnostyki Laboratoryjnej Oddział w Bydgoszczy oraz firmy Argenta serdecznie zapraszamy na zdalne posiedzenie naukowo-szkoleniowe, które odbędzie się 15 października (środa), o godz. 16:30.
Harmonogram spotkania:
16.30-16.35 – Powitanie oraz rozpoczęcie posiedzenia
– Dr hab. Iga Hołyńska-Iwan, prof. UMK, Katedra Patobiochemii i Chemii Klinicznej, Wydział Farmaceutyczny, Collegium Medicum im. L. Rydygiera w Bydgoszczy, Uniwersytet Mikołaja Kopernika
16.35-17.20 – Biochemiczne aspekty działania radiofarmaceutyków
– dr Jolanta Czuczejko, Zakład Medycyny Nuklearnej Centrum Onkologii w Bydgoszczy oraz Katedra Psychiatrii CM UMK
17.20-17.50 – Wykorzystanie nowoczesnych metod w diagnostyce immunochemicznej na przykładzie celiakii. Najnowsze rozwiązanie firmy Argenta
– Agata Stolarczyk, Project Manager, Biochemia i Immunochemia, Argenta Sp. z o.o.
17.50-18.00 – Pytania od uczestników i zakończenie posiedzenia
Zachęcamy do rejestracji i udziału w wydarzeniu!

Zdalne posiedzenie naukowo-szkoleniowe Polskiego Towarzystwa Diagnostyki Laboratoryjnej Oddział we Wrocławiu
Materiały do pobrania:
PChN w praktyce laboratoryjnej – jak rozpoznać pierwsze sygnały ostrzegawcze?
– dr n. med. Dorota Bartoszek, Katedra Nauk Przedklinicznych, Farmakologii i Diagnostyki Medycznej, Wydział Medyczny Politechniki Wrocławskiej, Zakład Diagnostyki Laboratoryjnej, 4 Wojskowy Szpital Kliniczny z Polikliniką SP ZOZ we Wrocławiu
Pobierz
Mikroskopia automatyczna badania osadu moczu. Mikroskopia kontrastu fazowego czy obrazowanie przepływowe?
– Daniel Tvrdoń, Country and International Project Manager, Argenta Sp. z o.o.
Pobierz
Erytrocyturia kłębuszkowa w praktyce diagnostycznej – rola zaawansowanej analizy osadu moczu
– dr n. med. Marcelina Żabińska, Katedra Nauk Przedklinicznych, Farmakologii i Diagnostyki Medycznej, Wydział Medyczny Politechniki Wrocławskiej, Zakład Diagnostyki Laboratoryjnej, 4 Wojskowy Szpital Kliniczny z Polikliniką SP ZOZ we Wrocławiu
Pobierz

Zdalne posiedzenie naukowo-szkoleniowe Polskiego Towarzystwa Diagnostyki Laboratoryjnej Oddział we Wrocławiu
Szanowni Państwo,
w imieniu Polskiego Towarzystwa Diagnostyki Laboratoryjnej Oddział we Wrocławiu oraz firmy Argenta serdecznie zapraszamy na zdalne posiedzenie naukowo-szkoleniowe, które odbędzie się 25 września (czwartek), o godz. 16:30.
Harmonogram spotkania:
16.30-16.35 – Powitanie oraz rozpoczęcie Posiedzenia
– dr n. med. Olga Loska-Rytwińska, Zakład Diagnostyki Laboratoryjnej 4 Wojskowy Szpital Kliniczny z Polikliniką SP ZOZ we Wrocławiu
16.35-16.55 – PChN w praktyce laboratoryjnej – jak rozpoznać pierwsze sygnały ostrzegawcze?
– dr n. med. Dorota Bartoszek, Katedra Nauk Przedklinicznych, Farmakologii i Diagnostyki Medycznej, Wydział Medyczny Politechniki Wrocławskiej, Zakład Diagnostyki Laboratoryjnej, 4 Wojskowy Szpital Kliniczny z Polikliniką SP ZOZ we Wrocławiu
16.55-17.25 – Mikroskopia automatyczna badania osadu moczu. Mikroskopia kontrastu fazowego czy obrazowanie przepływowe?
– Daniel Tvrdoń, Country and International Project Manager, Argenta Sp. z o.o.
17.25-17.45 – Erytrocyturia kłębuszkowa w praktyce diagnostycznej – rola zaawansowanej analizy osadu moczu
– dr n. med. Marcelina Żabińska, Katedra Nauk Przedklinicznych, Farmakologii i Diagnostyki Medycznej, Wydział Medyczny Politechniki Wrocławskiej, Zakład Diagnostyki Laboratoryjnej, 4 Wojskowy Szpital Kliniczny z Polikliniką SP ZOZ we Wrocławiu
17.45-18.00 – Pytania od uczestników i zakończenie Posiedzenia
Zachęcamy do rejestracji i udziału w wydarzeniu!

Webinar "Liczenie kolonii nowej generacji: Sztuczna inteligencja jako Twój partner w laboratorium"
Jak zautomatyzować liczenie kolonii i zwiększyć wiarygodność wyników dzięki wykorzystaniu sztucznej inteligencji? Zapraszamy na ekspercki webinar organizowany przez naszego partnera - Interscience.
W programie webinaru:
- Rozwój modeli sztucznej inteligencji wspierających liczenie kolonii
- Przegląd dokładności i wydajności systemu Scan AI
- Ciągły i dostosowywalny rozwój systemu Scan AI
- Sesja pytań i odpowiedzi z ekspertami

Webinar dot. klinicznych interpretacji inwazyjnych zakażeń grzybiczych
Materiały do pobrania:
Płytki Sensititre do AST grzybów – prawidłowy odczyt, zalecenia i wskazówki – Ewa Kaniuk, Technical Sales Specialist, Thermo Fisher Scientific Pobierz
Nowoczesne podejście do diagnostyki sepsy: dRAST w praktyce – dr Dawid Kościelniak, Specjalista ds. Aplikacji, Argenta Sp. z o.o. Pobierz
Inwazyjne zakażenia grzybicze – interpretacje kliniczne – dr n. med. Beata Sulik-Tyszka, Zakład Mikrobiologii Klinicznej NIO-PIB, Warszawa Pobierz

Posiedzenie naukowo-szkoleniowe PTM Olsztyn
Materiały do pobrania:
Zapalenie i zakażenie: Misja przetrwania 2.0 – Jadwiga Ślusarska-Kopala, Konsultant wojewódzki w dziedzinie mikrobiologii lekarskiej Pobierz
Biologia molekularna w diagnostyce medycznej. Identyfikacja lekooporności metodą LAMP-PCR – Daria Kalkowska, Specjalista ds. Aplikacji, Argenta Sp. z o.o. Pobierz
Wysokie ciśnienie, wysokie ryzyko? Transfer genów oporności na antybiotyki u Listeria monocytogenes pod wpływem technologii wysokich ciśnień – mgr inż. Patryk Wiśniewski, doktorant, asystent badawczy, Wydział Nauki o Żywności, UWM Pobierz

Zebranie naukowo-szkoleniowe Polskiego Towarzystwa Diagnostyki Laboratoryjnej Oddział w Gdańsku
Szanowni Państwo,
serdecznie zapraszamy do udziału w wydarzeniu edukacyjnym dedykowanym diagnostom laboratoryjnym, którego celem jest przedstawienie najnowszych rozwiązań w zakresie diagnostyki przyłóżkowej oraz zastosowania nowoczesnych analizatorów POCT w praktyce klinicznej.
18:00–18:10 | Powitanie uczestników
dr hab. Agnieszka Jankowska-Kulawy– Przewodnicząca PTDL Oddział Gdańsk
18:10–19:00 | SOR - miejsce, gdzie czas liczy się najbardziej
Arkadiusz Wnuk - Koordynator POCT w Szpitalu Uniwersyteckim w Krakowie
19:00–19:15 | Portfolio analizatorów POCT i ich zastosowanie w ofercie Argenta
Dominik Latoszek – Key Account Manager ds. Rozwoju Rynku Klinicznego, Dział Klinika Argenta Sp. z o.o.
19:15 | Test dla uczestników
Za udział w konferencji diagnostom laboratoryjnym przysługują 2 punkty edukacyjne, zgodnie z Rozporządzeniem Ministra Zdrowia z dnia 7 grudnia 2023 r. w sprawie ustawicznego rozwoju zawodowego diagnosty laboratoryjnego.

Zebranie naukowo-szkoleniowe Polskiego Towarzystwa Diagnostyki Laboratoryjnej Oddział w Białymstoku
Szanowni Państwo,
serdecznie zapraszamy do udziału w wydarzeniu edukacyjnym skierowanym do diagnostów laboratoryjnych, którego celem jest przybliżenie najnowszych rozwiązań w zakresie oznaczania troponiny w warunkach POCT oraz zaprezentowanie nowoczesnych analizatorów dostępnych na rynku.
17:00–17:10 | Powitanie uczestników
dr hab. Małgorzata Rusak – Przewodnicząca PTDL Oddział Białystok
17:10–17:40 | Nowe możliwości oznaczania troponiny metodami wysoce czułymi w warunkach POCT
Dr Katarzyna Kowalska-Piastun – Siemens Healthcare Sp. z o.o.
17:45–18:20 | Portfolio analizatorów POCT i ich zastosowanie w ofercie Argenta
Adrianna Olejniczak – Key Account Manager ds. Rozwoju Rynku Klinicznego, Dział Klinika firmy Argenta Sp. z o.o.
18:20 | Test dla uczestników
Za udział w konferencji diagnostom laboratoryjnym przysługują 2 punkty edukacyjne, zgodnie z Rozporządzeniem Ministra Zdrowia z dnia 7 grudnia 2023 r. w sprawie ustawicznego rozwoju zawodowego diagnosty laboratoryjnego.
Rejestracja na zdalne Posiedzenie naukowo-szkoleniowe PTM Olsztyn
W imieniu Polskiego Towarzystwa Mikrobiologów Odział w Olsztynie oraz firmy Argenta serdecznie zapraszamy na Posiedzenie naukowo-szkoleniowe.
Harmonogram spotkania:
16.00-16.05 – Powitanie oraz rozpoczęcie Posiedzenia
– dr hab. inż. Wioleta Chajęcka-Wierzchowska, prof. UWM Przewodnicząca PTM Oddział w Olsztynie
16.05-16.35 – Zapalenie i zakażenie: Misja przetrwania 2.0
– Jadwiga Ślusarska-Kopala, Konsultant wojewódzki w dziedzinie mikrobiologii lekarskiej
16.35-17.05 – Biologia molekularna w diagnostyce medycznej. Identyfikacja lekooporności metodą LAMP-PCR
– Daria Kalkowska, Specjalista ds. Aplikacji, Argenta Sp. z o.o.
17.05-17.35 – Wysokie ciśnienie, wysokie ryzyko? Transfer genów oporności na antybiotyki u Listeria monocytogenes pod wpływem technologii wysokich ciśnień
– mgr inż. Patryk Wiśniewski, doktorant, asystent badawczy, Katedra Mikrobiologii Żywności, Technologii i Chemii Mięsa, Wydział Nauki o Żywności, UWM
17.35-17.50 – Pytania od uczestników i zakończenie Posiedzenia

Rejestracja na webinar dot. klinicznych interpretacji inwazyjnych zakażeń grzybiczych
Szanowni Państwo,
wychodząc naprzeciw Państwa potrzebom i oczekiwaniom zachęcamy do udziału w webinarze naukowym dotyczącym klinicznych interpretacji inwazyjnych zakażeń grzybiczych, który odbędzie się 14 maja (środa), o godz. 17:00.
Harmonogram spotkania:
17.00-17.05 – Powitanie oraz rozpoczęcie wydarzenia
17.05-17.25 – Płytki Sensititre do AST grzybów – prawidłowy odczyt, zalecenia i wskazówki
– Ewa Kaniuk, Technical Sales Specialist, Thermo Fisher Scientific
17.25-17.45 – Nowoczesne podejście do diagnostyki sepsy: dRAST w praktyce
– dr Dawid Kościelniak, Specjalista ds. Aplikacji, Argenta Sp. z o.o.
17.45-18:30 – Inwazyjne zakażenia grzybicze – interpretacje kliniczne
– Dr n. med. Beata Sulik-Tyszka, Zakład Mikrobiologii Klinicznej NIO-PIB, Warszawa
18.30-18.45 – Pytania od uczestników i zakończenie wydarzenia
Zachęcamy do rejestracji i udziału w wydarzeniu!

UWAGA ZMIANA TERMINU! Zebranie naukowo-szkoleniowe Polskiego Towarzystwa Diagnostyki Laboratoryjnej Oddział w Białymstoku
Program wydarzenia:
👩⚕️17:00–17:10 | Powitanie uczestników
dr hab. Małgorzata Rusak – Przewodnicząca PTDL Oddział Białystok
👩⚕️17:10–17:40 | Nowe możliwości oznaczania troponiny metodami wysoceczułymi w warunkach POCT
Dr Katarzyna Kowalska-Piastun – Siemens Healthcare Sp. z o.o.
👩⚕️17:45–18:20 | Portfolio analizatorów POCT i ich zastosowanie w ofercie Argenta
Adrianna Olejniczak – Key Account Manager ds. Rozwoju Rynku Klinicznego, Dział Klinika
👩⚕️18:20 | Test dla uczestników
📚 Za udział w wydarzeniu diagności laboratoryjni otrzymują 2 punkty edukacyjne, zgodnie z rozporządzeniem Ministra Zdrowia z dnia 7 grudnia 2023 r. w sprawie ustawicznego rozwoju zawodowego diagnosty laboratoryjnego (Dz. U. 2023, poz. 2684).

Zadbaj o poprawę bezpieczeństwa w pracy – odpowiedni dobór środków ochrony indywidualnej na przykładzie rękawic jednorazowych
W trakcie spotkania:
-
dowiesz się, jakie czynniki należy brać pod uwagę przy wyborze rękawic ochronnych,
-
poznasz różnice między materiałami i konstrukcjami rękawic,
-
uzyskasz praktyczne wskazówki dotyczące zastosowania produktów w konkretnych środowiskach pracy.
Prelegentka:
Iwona Miąsik
Senior Product Group Manager w firmie Mercator Medical – ekspertka z wieloletnim doświadczeniem w zakresie produktów ochrony indywidualnej, szczególnie rękawic jednorazowych wykorzystywanych w laboratoriach, służbie zdrowia i przemyśle.
Webinar będzie doskonałą okazją do zadania pytań i rozwiania wątpliwości związanych z doborem i użytkowaniem środków ochrony indywidualnej.
Do zobaczenia online!
Zespół bestlabs.pl

Posiedzenie naukowo-szkoleniowe PTM Bydgoszcz
Materiały do pobrania:
Nowoczesne podejście do diagnostyki sepsy: dRAST w praktyce – dr Dawid Kościelniak, Specjalista ds. Aplikacji, Argenta Sp. z o.o. Pobierz
Lekowrażliwość pałeczek Gram-ujemnych z dodatnich hodowli krwi – dRAST vs AST – dr n. med. Tomasz Bogiel, Zakład Mikrobiologii Klinicznej, Szpital Uniwersytecki Nr 1 im. Dr. A. Jurasza w Bydgoszczy Pobierz
System Sensititre partner w walce z lekoopornością – nowe antybiotyki, nowe płytki, nowe możliwości – Ewa Kaniuk, Thermo FisherScientific, Technical Sales Specialist Pobierz
Oznaczanie lekowrażliwości bakterii wybrednych metodą mikrorozcieńczeń z wykorzystaniem ARIS HiQ AST System – mgr Maciej Pochowski, Zakład Diagnostyki Mikrobiologicznej, Kujawsko-Pomorskie Centrum Pulmonologii w Bydgoszczy Pobierz

Diagnostyka HPV w Nowej Rzeczywistości – Zasady, Refundacja, Praktyka
Materiały do pobrania

Rejestracja na posiedzenie naukowo-szkoleniowe PTM Bydgoszcz
W imieniu Polskiego Towarzystwa Mikrobiologów Odział w Bydgoszczy oraz firmy Argenta serdecznie zapraszamy na zdalne posiedzenie naukowo-szkoleniowe.
DATA 3.04.2025 / godz. 16.00
Harmonogram spotkania:
16.00-16.05 – Powitanie oraz rozpoczęcie spotkania – dr n. med. Tomasz Bogiel, Sekretarz PTM Oddział w Bydgoszczy
16.05-16.25 – Nowoczesne podejście do diagnostyki sepsy: dRAST w praktyce – dr Dawid Kościelniak, Specjalista ds. Aplikacji, Argenta Sp. z o.o.
16.25-16.50 – Lekowrażliwość pałeczek Gram-ujemnych z dodatnich hodowli krwi – dRAST vs AST – dr n. med. Tomasz Bogiel, Zakład Mikrobiologii Klinicznej, Szpital Uniwersytecki Nr 1 im. Dr. A. Jurasza w Bydgoszczy
16.50-17.10 – System Sensititre partner w walce z lekoopornością – nowe antybiotyki, nowe płytki, nowe możliwości – Ewa Kaniuk, Thermo Fisher Scientific, Technical Sales Specialist
17.10-17.35 – Oznaczanie lekowrażliwości bakterii wybrednych metodą mikrorozcieńczeń z wykorzystaniem ARIS HiQ AST System – mgr Maciej Pochowski, Zakład Diagnostyki Mikrobiologicznej, Kujawsko-Pomorskie Centrum Pulmonologii w Bydgoszczy
17.35-17.45 – Sesja Q&A
17.45 – Podsumowanie i zakończenie spotkania – dr n. med. Tomasz Bogiel, sekretarz PTM Oddział w Bydgoszczy

Akademia Diagnostyki Argenta
Materiały do pobrania:

Zebranie naukowo-szkoleniowe
Materiały do pobrania:
Diagnostyka mikrobiologiczna sepsy. Co mikrobiolog może zaproponować klinicyście – dr n. biol. Katarzyna Semczuk: Pobierz
Genetyczne powiązania oporności na leki wśród E. coli i Klebsiella spp.: rola mobilnych elementów w rozprzestrzenianiu lekooporności u szczepów klinicznych i izolowanych ze ścieków szpitalnych – dr Damian Rolbiecki: Pobierz
Antybiotykooporność oraz wirulencja szczepów S. aureus wyizolowanych z łańcucha produkcji polskich serów zagrodowych – dr inż. Joanna Gajewska: Pobierz
Oznaczanie lekowrażliwości z wykorzystaniem najnowszych technologii – Kinga Dorawa: Pobierz

Akademia Bezpieczeństwa Żywności Argenta
Materiały do pobrania:
Zarządzanie alergenami na produkcji – czy mam pewność, że procedury są skuteczne – Małgorzata Krzepkowska, Food Safety & Quality Expert, J. S. Hamilton Poland: Pobierz
Badanie pozostałości antybiotyków w mleku przy pomocy szybkich testów jakościowych – Martyna Żyłka, Integra Diagnostic: Pobierz
Pozostałości leków weterynaryjnych w produktach spożywczych – wstęp do zagadnienia oraz wykorzystanie testów ELISA w diagnostyce – Daniel Dolata, Gold Standard Diagnostic: Pobierz
Metody diagnostyczne w identyfikacji patogenów żywnościowych – wyzwania i przyszłość – Marta Szlązak, Kierownik Produktu, Argenta: Pobierz

Zebranie Naukowo-Szkoleniowe PTM Olsztyn
Polskie Towarzystwo Mikrobiologów Oddział w Olsztynie oraz firma #Argenta mają zaszczyt zaprosić na Zebranie naukowo-szkoleniowe, które odbędzie się:
👉 Data: Wtorek, 10 grudnia 2024
🕑 Czas: 16:30–18:50
📢 Rejestracja https://bit.ly/3Zt9k3o
Harmonogram wydarzenia:
🛎️ 16.30-16.35 – Powitanie oraz rozpoczęcie Zebrania – dr hab. inż. Wioleta Chajęcka-Wierzchowska, Przewodniczący PTM OT Olsztyn
🛎️ 16.35-17.05 – Diagnostyka mikrobiologiczna sepsy. Co mikrobiolog może zaproponować klinicyście – dr n. biol. Katarzyna Semczuk, Zakład Mikrobiologii i Immunologii Klinicznej, Instytut „Pomnik – Centrum Zdrowia Dziecka”
🛎️ 17.05-17.35 – Genetyczne powiązania oporności na leki wśród E. coli i Klebsiella spp.: rola mobilnych elementów w rozprzestrzenianiu lekooporności u szczepów klinicznych i izolowanych ze ścieków szpitalnych – dr Damian Rolbiecki, Europejskie Regionalne Centrum Ekohydrologii, Polskiej Akademii Nauk
🛎️ 17.35-18.05 – Antybiotykooporność oraz wirulencja szczepów S. aureus wyizolowanych z łańcucha produkcji polskich serów zagrodowych – dr inż. Joanna Gajewska, Wydział Nauki o Żywności, Uniwersytet Warmińsko-Mazurski w Olsztynie
🛎️ 18.05-18.35 – Oznaczanie lekowrażliwości z wykorzystaniem najnowszych technologii – Kinga Dorawa, Specjalista ds. Aplikacji, Argenta Sp. z o.o.
🛎️ 18.35-18.50 – Pytania od uczestników i zakończenie Zebrania
Wydarzenie jest dedykowane specjalistom zainteresowanym mikrobiologią i diagnostyką kliniczną.
Serdecznie zachęcamy do udziału!

Akademia Bezpieczeństwa Żywności Argenta
Dzień 1. Bezpieczeństwo żywności - jakość produkcji
4 grudnia, 12.00-13.45
12.00-12.05 - Rozpoczęcie spotkania – Krystian Gołdyn, Dyrektor Marketingu, Argenta
12.05-12.35 - Zarządzanie alergenami na produkcji – czy mam pewność, że procedury są skuteczne – Małgorzata Krzepkowska, Food Safety & Quality Expert, J. S. Hamilton Poland
12.35-13.05 - Badanie pozostałości antybiotyków w mleku przy pomocy szybkich testów jakościowych – Martyna Żyłka, Integra Diagnostic
13.05-13.35 - Pozostałości leków weterynaryjnych w produktach spożywczych – wstęp do zagadnienia oraz wykorzystanie testów ELISA w diagnostyce – Daniel Dolata, Gold Standard Diagnostic
13.35-13.45 - Sesja Q&A i zakończenie spotkania
Link do rejestracji: https://bit.ly/ABZ_Argenta_Bezpieczenstwo_zywnosci
Dzień 2. Badania mikrobiologiczne żywności – analizy i normy
5 grudnia, g. 12.00-13.45
12.00-12.05 - Rozpoczęcie spotkania – Krystian Gołdyn, Dyrektor Marketingu, Argenta
12.05-12.35 - Zasady ustalania w specyfikacji produktu zakresu parametrów mikrobiologicznych i metod badań oraz dopuszczalnych limitów pod kątem znaczenia i skutków – Anna Bugajewska, Ekspert Mérieux NutriSciences
12.35-13.05 - Jak usprawnić analizę patogenów w żywności metodą molekularną – Piotr Gutry, Field Application Specialist, Thermo Fisher Scientific
13.05-13.35 - Metody diagnostyczne w identyfikacji patogenów żywnościowych – wyzwania i przyszłość – Marta Szlązak, Kierownik Produktu, Argenta
13.35-13.45 - Sesja Q&A i zakończenie spotkania
Link do rejestracji: https://bit.ly/ABZ_Argenta_Badania_mikrobiologiczne_zywnosci

Szkoła Diagnostyki Weterynaryjnej Argenta
Materiały do pobrania

Posiedzenie naukowo-szkoleniowe PTM Oddział w Bydgoszczy
Materiały do pobrania:
Od naturalnej oporności do ECOFF - trudna droga do właściwej interpretacji wyników oznaczeń antybiotykowrażliwości –dr hab. Joanna Kwiecińska-Piróg, prof. UMK: Pobierz
Nowe opcje terapeutyczne w leczeniu zakażeń wywołanych wieloantybiotykoopornymi szczepami bakterii – dr n. med. Joanna Kubiak-Pulkowska: Pobierz
Oznaczanie lekowrażliwości w diagnostyce zakażeń krwi – Kinga Dorawa: Pobierz

Akademia Diagnostyki Argenty
Materiały do pobrania:
Standardy organizacyjne POCT - Arkadiusz Wnuk, Koordynator POCT w Szpitalu Uniwersyteckim w Krakowie: Pobierz
Rola narzędzi IT w zarządzaniu POCT w oparciu o Rozporządzenie Ministra Zdrowia z dnia 23.10.2023 r. - Marcin Gajda, Siemens Healthcare Sp. z o.o.: Pobierz
Diagnostyka zespołów mieloproliferacyjnych z użyciem wieloparametrowej morfologii krwi - Roman Pińkowski, Hematology Country Project Manager, Argenta: Pobierz

Zaproszenie na webinarium naukowe
🪪 Rejestracja: https://lnkd.in/dw5U2sBj
W imieniu hasztag#Polskiego hasztag#Towarzystwa hasztag#Mikrobiologów hasztag#Oddział w hasztag#Bydgoszczy oraz firmy hasztag#Argenta, serdecznie zapraszamy na nasze nadchodzące webinarium naukowe. W ramach obchodów Europejskiego Dnia Wiedzy o hasztag#Antybiotykach oraz Światowego Tygodnia Wiedzy o Antybiotykach, które odbywają się od 18 do 24 listopada, nasze spotkanie poświęcone będzie najnowszym wyzwaniom związanym z hasztag#antybiotykoopornością.
📆 Harmonogram spotkania:
📌 16.00-16.05 – Powitanie oraz rozpoczęcie Zebrania – dr Alicja Sękowska, Zastępca Przewodniczącej PTM Oddział w Bydgoszczy, dr Tomasz Bogiel, Sekretarz PTM Oddział w Bydgoszczy
📌 16.05-16.35 – O od naturalnej oporności do ECOFF - trudna droga do właściwej interpretacji wyników oznaczeń antybiotykowrażliwości – dr hab. Joanna Kwiecińska-Piróg, prof. UMK; Katedra Mikrobiologii Collegium Medicum UMK oraz Zakład Mikrobiologii Klinicznej Szpital Uniwersytecki Nr 1 im. dr. A. Jurasza w Bydgoszczy
📌 16.35-17.05 – Nowe opcje terapeutyczne w leczeniu zakażeń wywołanych wieloantybiotykoopornymi szczepami bakterii – dr n. med. Joanna Kubiak-Pulikowska, Zespół Kontroli Zakażeń Szpitalnych, Szpital Uniwersytecki Nr 2 im. dr. J. Biziela w Bydgoszczy
📌 17.05-17.25 – Oznaczanie lekowrażliwości w diagnostyce zakażeń krwi – Kinga Dorawa, Specjalista ds. Aplikacji, Argenta Sp. z o.o.
📌 17.25-17.40 – Sesja Q&A
📌 17.40-17.45 – Podsumowanie – dr Tomasz Bogiel - sekretarz PTM Oddział w Bydgoszczy

Akademia Diagnostyki Argenty
Nagroda Nobla a skuteczna diagnostyka prenatalna oparta na wiarygodnych badaniach biochemicznych pozbawionych interferencji w świetle nowelizacji rozporządzenia Ministra Zdrowia - Dr n. med. Marcin Naklicki, Clinical Demand Specialist, Speciality Diagnostics Group, Thermo Fisher Scientific
Diagnostyka zaburzeń trombopoezy z użyciem nowoczesnych parametrów płytkowych - Roman Pińkowski, Hematology Country Project Manager, Argenta

System Sensititre ThermoFisher Scientific - Oznaczanie MIC metodą mikrorozcieńczeń w bulionie
Materiał do pobrania

Kliniczne interpretacje inwazyjnych zakażeń grzybiczych wg rekomendacji EUCAST i CLSI
Materiał do pobrania

Akademia Diagnostyki Argenty
Mikroskopia automatyczna badania osadu moczu. Różnicowanie erytrocytów nie tylko na świeże oraz wyługowane, czy to możliwe? - Daniel Tvrdoň, Country and International Project Manager
Informacje o urządzeniach:
- MUS-3600 Dirui - Zobacz katalog
- Urised Cascade - Zobacz katalog
Diagnostyka niedokrwistości z użyciem nowoczesnych parametrów czerwonokrwinkowych i retikulocytarnych - Roman Pińkowski, Hematology Country Project Manager

Automatyczne metody identyfikacji drobnoustrojów - Autof MS2600
Materiał do pobrania

Akademia Diagnostyki Argenty
Zachęcamy do udziału w VIII edycji cyklu webinarów „Akademia Diagnostyki Argenty”. Wydarzenia obejmują zagadnienia z obszarów diagnostyki laboratoryjnej – analizy moczu, hematologii, biochemii i biologii molekularnej.
Harmonogram wydarzeń:
- Data 30 września, g. 15.00
Mikroskopia automatyczna badania osadu moczu. Różnicowanie erytrocytów nie tylko na świeże oraz wyługowane, czy to możliwe? - Daniel Tvrdoň, Country and International Project Manager
Diagnostyka niedokrwistości z użyciem nowoczesnych parametrów czerwonokrwinkowych i retikulocytarnych - Roman Pińkowski, Hematology Country Project Manager
Rejestracja: link
- Data 28 października, g. 15.00
Nagroda Nobla a skuteczna diagnostyka prenatalna oparta na wiarygodnych badaniach biochemicznych pozbawionych interferencji w świetle nowelizacji rozporządzenia Ministra Zdrowia - Dr n. med. Marcin Naklicki, Clinical Demand Specialist, Speciality Diagnostics Group, Thermo Fisher Scientific
Diagnostyka zaburzeń trombopoezy z użyciem nowoczesnych parametrów płytkowych - Roman Pińkowski, Hematology Country Project Manager, Argenta
Rejestracja: link
- Data 25 listopada, g. 15.00
Nowoczesne podejścia w diagnostyce POCT: Innowacje i zastosowania w praktyce
Diagnostyka zespołów mieloproliferacyjnych z użyciem wieloparametrowej morfologii krwi - Roman Pińkowski, Hematology Country Project Manager
Rejestracja: link
- Data 16 grudnia, g. 15.00
Przyszłość Diagnostyki Molekularnej: Jak mPOCT zmienia Ochronę Zdrowia - Daria Kalkowska, Specjalista ds. Aplikacji
Znaczenie kliniczno-diagnostyczne nowoczesnych parametrów hematologicznych mierzonych przy użyciu analizatorów Mindray serii BC6000 i BC700 - Roman Pińkowski, Hematology Country Project Manager
Rejestracja: link

Szkoła Diagnostyki Weterynaryjnej Argenta
Zachęcamy do udziału w cyklu webinarów „Szkoła Diagnostyki Weterynaryjnej Argenta”. Wraz z naszymi ekspertami omówimy zagadnienia z obszarów automatycznej metody identyfikacji drobnoustrojów, oznaczania MIC metodą mikrorozcieńczeń w bulionie oraz wykrywania pozostałości antybiotyków w mięsie.
Harmonogram wydarzeń:
Automatyczne metody identyfikacji drobnoustrojów - Autof MS2600
25 września 2024, godz. 16:00
Rejestracja: link
System Sensititre ThermoFisher Scientific - Oznaczanie MIC metodą mikrorozcieńczeń w bulionie
23 października 2024, godz. 16:00
Rejestracja: link
Wykrywanie antybiotyków w mięsie za pomocą metody ELISA – Automatyzacja procesu przy użyciu systemu BOLT
27 listopada 2024, godz. 13:00
Rejestracja: link

Automatyzacja pracy gabinetu, zastosowanie analizatora biochemicznego Noahcali-100
Materiał do pobrania

Diagnostyka wskaźników biochemicznych z wykorzystaniem analizatora Noahcali-100
Materiały do pobrania

Automatyczny analizator biochemiczny Noahcali-100
Materiały do pobrania

Szkoła Diagnostyki Weterynaryjnej Argenta
Zachęcamy do udziału w cyklu webinarów „Szkoła Diagnostyki Weterynaryjnej Argenta”. Wydarzenia obejmują zagadnienia z obszarów biochemii weterynaryjnej.
Harmonogram wydarzeń:
Automatyczny analizator biochemiczny Noahcali-100
17 lipca 2024, godz. 13:00
Rejestracja: link
Diagnostyka wskaźników biochemicznych z wykorzystaniem analizatora Noahcali-100
7 sierpnia 2024, godz. 13:00
Rejestracja: link
Automatyzacja pracy gabinetu, zastosowanie analizatora biochemicznego Noahcali-100
28 sierpnia 2024, godz. 13:00
Rejestracja: link

Diagnostyka lekooporności bakterii oraz precyzyjne wykrywanie patogenów metodami biologii molekularnej
Prezentacja do pobrania

Jak bezpiecznie zdiagnozować zakażenia układu oddechowego, płciowego i pokarmowego - szybkie rozwiązania molekularne
Prezentacja do pobrania

Dostępne i wszechstronne rozwiązania w diagnostyce molekularnej M. Tuberculosis oraz MDR M. Tuberculosis. Ewaluacja wyników
Prezentacja do pobrania

Automatyzacja diagnostyki chorób układu pokarmowego i oddechowego – testy H.pylori Ag i Legionella Ag
Prezentacja do pobrania

Wydajność badań biochemicznych
Prezentacje do pobrania

Nowoczesne technologie w hematologii - analiza przypadków z użyciem mikroskopii w czasie rzeczywistym
Prezentacja do pobrania

Nowoczesne ujęcie diagnostyki immunochemicznej - cukrzyca typu I
Prezentacja do pobrania

Automatyczne metody analizy ogólnej moczu
Prezentacje do pobrania

Szybka i automatyczna diagnostyka stanów zapalnych - test CRP
Prezentacja do pobrania

Wysoka wydajność Twojego laboratorium w sezonie przeziębień – testy Strep A AG
Prezentacja do pobrania

Szybka i automatyczna diagnostyka CRP w Twoim gabinecie
Prezentacja do pobrania
Zebranie naukowo-szkoleniowe PTM Oddział w Olsztynie i firmy Argenta
Materiał do pobrania

Akademia Bezpieczeństwa Żywności - Dzień I
Materiały do pobrania:
1. Szybkie metody potwierdzania obecności patogenów w hodowlach zgodnie ze standardami ISO.

Akademia Bezpieczeństwa Żywności - Dzień II
Materiały do pobrania:
1. Najczęstsze wyzwania w oznaczaniu patogenów metodą PCR i jak sobie z nimi radzić
2. Emulsyjno-kropelkowa technologia PCR
3. Zafałszowania suplementów diety
4. MALDI TOF jako nowoczesna metoda analityczna w badaniu żywności

Szybka i automatyczna diagnostyka CRP w Twoim gabinecie
Zebranie naukowo-szkoleniowe PTM Oddział w Bydgoszczy i firmy Argenta
Materiał do pobrania

Systemy zamknięte jako szybkie i wszechstronne rozwiązanie w diagnostyce molekularnej chorób zakaźnych oraz analizie lekooporności bakterii
Materiał do pobrania

Szybka i automatyczna diagnostyka CRP w Twoim gabinecie
Materiał do pobrania

Nowoczesne rozwiązania hematologiczne
Materiał do pobrania

Automatyzacja, wydajność, precyzja - nowoczesne ujęcie diagnostyki biochemicznej i immunochemicznej
Materiał do pobrania

Mikroskopia automatyczna badania osadu moczu. Mikroskopia kontrastu fazowego czy obrazowanie przepływowe?
Materiał do pobrania

Szybka i automatyczna diagnostyka CRP w Twoim gabinecie
Materiał do pobrania

Warsztaty i forum wiedzy managerskiej. FoodFakty Science 4 Business
Materiały do pobrania
Fenotypowe MIC w ciągu 4 godzin bezpośrednio z dodatnich posiewów krwi – teoria i praktyka
Materiał do pobrania

Webinar - Alergeny i mykotoksyny
Materiały do pobrania

Webinar - Czy jest możliwa analiza parametru OB razem z morfologią 5 DIFF
Materiał do pobrania

Webinar - Standard M10: RT-PCR + LAMP w jednym systemie dla lepszej diagnostyki
Materiał do pobrania

Webinar - Monitoring środowiska produkcyjnego żywności
Materiał do pobrania

Zebranie naukowo-szkoleniowe Oddziału PTDL w Kielcach
Materiały do pobrania

Webinar - Prezentacja SD Biosensor F200!
Materiały do pobrania

Zebranie naukowo-szkoleniowe Oddziału PTDL w Białymstoku
Materiały do pobrania

Webinar - Prezentacja SD Biosensor F200!
Szanowni Państwo,
serdecznie zapraszamy na prezentację SD Biosensor F200
13:00-13:05 Powitanie i rozpoczęcie spotkania,
13:05-13:35 Opis techniczny urządzenia SD BIOSENSOR F200
13:35-13:45 Dyskusja
13:45-14:00 Podsumowanie spotkania

Bezpieczeństwo mikrobiologiczne w farmacji i przemyśle kosmetycznym - materiały do pobrania
Materiały do pobrania
Webinar pt."Bezpieczeństwo mikrobiologiczne w farmacji i przemyśle kosmetycznym".
1. dr hab. Jolanta Długaszewska, UAM: „Bezpieczeństwo mikrobiologiczne i aspekty jakości produktów leczniczych"
2. Marta Kozieł, Argenta: „Zastosowanie cytometrii przepływowej w mikrobiologicznych badaniach kosmetyków i żywności”.
3. Andrei Ihnatsenka, Microbiologics: „Growth Promotion Testing in Pharmaceutical Industry”.

Technika PCR w analizie bezpieczeństwa żywności i próbek środowiskowych - materiały do pobrania
Materiały do pobrania
Webinar pt. "Technika PCR w analizie bezpieczeństwa żywności i próbek środowiskowych".
1. Ricardo Silva e Sousa, Eurofins GeneScan Technologies GmbH: “Pathogen detection in food samples – PCR comparison to culturing and ELISA”
2. Bogusław Wiera, Argenta: „Zalety wykorzystania techniki multipleks PCR”.
3. Aleksandra Helbig, Eurofins Polska: „Badanie Covid-19 w próbkach środowiskowych – doświadczenia grupy Eurofins”.

Najczęściej występujące dermatozy o etiologii bakteryjnej u psów – postępowanie diagnostyczne - Szkoła Diagnostyki Weterynaryjnej Argenta
Szanowni Państwo,
Serdecznie zapraszamy do udziału w cyklu szkoleń internetowych- webinarów, dedykowanych specjalnie diagnostyce weterynaryjnej. Webinary to doskonały wstęp do szkoleń warsztatowych. Cykl szkoleń prowadzimy w tematyce diagnostycznej i analityki weterynaryjnej.Uczestnicy otrzymują materiały szkoleniowe i certyfikat uczestnictwa. Istnieje również możliwość zadawania pytań prelegentowi po zakończeniu prezentacji oraz kontakt mailowy.
TERMIN: 19.04.2022, 17:00 – 19:00
CZAS TRWANIA: 1 godzin
SZKOLENIE BEZPŁATNE
CEL SZKOLENIA: Szkolenie jest realizowane w ramach cyklu webinarów Szkoły Diagnostyki Weterynaryjnej Argenta obejmujących zagadnienia z obszarów analityki ogólnej, mikrobiologii oraz cytologii weterynaryjnej wykorzystywanych w codziennej pracy lekarza klinicysty.
UCZESTNICY SZKOLENIA: szkolenie skierowane jest do lekarzy weterynarii, diagnostów laboratoryjnych, techników i osób pracujących w laboratoriach, którzy planują poszerzyć wiedzę i umiejętności z tematyki najczęściej występujących bakteryjnych chorób skóry, w tym zagadnień dotyczących podstaw badania mikrobiologicznego.
PROWADZĄCY: lek. wet. Ludwika Piwowarczyk, diagnosta laboratoryjny, Uniwersytet Medyczny im. K. Marcinkowskiego w Poznaniu
Mirosław Turuk, Kierownik ds. Kluczowych Klientów/ Dział Klinika - Diagnostyka Weterynaryjna, Argenta Sp. z o.o. Sp.k.
PROGRAM SZKOLENIA
- Wybrane bakteryjne choroby skóry - diagnostyka różnicowa
- Kiedy należy wykonać badania bakteriologiczne?
- Jak przygotować pacjenta do badania?
- Jak należy pobrać materiał, aby był diagnostyczny?
- Kiedy stosujemy antybiotykoterapię miejscową, a kiedy ogólnoustrojową?
- Najczęściej popełniane błędy w terapii
Szkolenie jest realizowane w ramach cyklu webinarów Szkoły Diagnostyki Weterynaryjnej Argenta, obejmującego zagadnienia z obszarów analityki ogólnej, mikrobiologii oraz cytologii weterynaryjnej wykorzystywanych w codziennej pracy lekarza klinicysty.
Każdy z uczestników webinariów otrzyma bezpłatny dostęp do materiałów w formie prezenatcji ppt.oraz certyfikat uczestnictwa.

Zakażenia układu moczowego (ZUM) u psów i kotów – aktualne wyzwania diagnostyczne - Szkoła Diagnostyki Weterynaryjnej Argenta
Szanowni Państwo,
Serdecznie zapraszamy do udziału w cyklu szkoleń internetowych- webinarów, dedykowanych specjalnie diagnostyce weterynaryjnej. Webinary to doskonały wstęp do szkoleń warsztatowych. Cykl szkoleń prowadzimy w tematyce diagnostyki i analityki weterynaryjnej. Uczestnicy otrzymują materiały szkoleniowe i certyfikat uczestnictwa. Istnieje również możliwość zadawania pytań prelegentowi po zakończeniu prezentacji oraz kontakt mailowy.
TERMIN: 24.05.2022, 20:00 – 21:00
CZAS TRWANIA: 1 godzin
SZKOLENIE BEZPŁATNE
CEL SZKOLENIA: Szkolenie jest realizowane w ramach cyklu webinarów Szkoły Diagnostyki Weterynaryjnej Argenta obejmujących zagadnienia z obszarów analityki ogólnej, mikrobiologii oraz cytologii weterynaryjnej wykorzystywanych w codziennej pracy lekarza klinicysty.
UCZESTNICY SZKOLENIA: szkolenie skierowane jest do lekarzy weterynarii, diagnostów laboratoryjnych, techników i osób pracujących w laboratoriach, którzy planują poszerzyć wiedzę i umiejętności z tematyki zakażeń układu moczowego (ZUM) u psów i kotów, w tym nawracających i uporczywych ZUM.
PROGRAM SZKOLENIA:
- Podstawowe informacje dotyczące ZUM
- Diagnostyka różnicowa
- Nawracające i uporczywe ZUM
- Jak właściwie pobrać materiał do badania
- Przegląd nowoczesnych technik i metod diagnostycznych
PROWADZĄCY:
lek. wet. Ludwika Piwowarczyk, diagnosta laboratoryjny, Uniwersytet Medyczny im. K. Marcinkowskiego w Poznaniu
Mirosław Turuk, Kierownik ds. Kluczowych Klientów/ Dział Klinika - Diagnostyka Weterynaryjna, Argenta Sp. z o.o. Sp.k.
Szkolenie jest realizowane w ramach cyklu webinarów Szkoły Diagnostyki Weterynaryjnej Argenta, obejmującego zagadnienia z obszarów analityki ogólnej, mikrobiologii oraz cytologii weterynaryjnej wykorzystywanych w codziennej pracy lekarza klinicysty.
Każdy z uczestników webinariów otrzyma bezpłatny dostęp do materiałów w formie prezenatcji ppt.oraz certyfikat uczestnictwa.

Diagnostyka Point of Care Testing (POCT) – jak ją wykorzystać do poprawy wyników leczenia chorób odkleszczowych u psów i kotów? - Szkoła Diagnostyki Weterynaryjnej Argenta
Szanowni Państwo,
Serdecznie zapraszamy do udziału w cyklu szkoleń internetowych- webinarów, dedykowanych specjalnie diagnostyce weterynaryjnej. Webinary to doskonały wstęp do szkoleń warsztatowych. Cykl szkoleń prowadzimy w tematyce diagnostyki i analityki weterynaryjnej.Uczestnicy otrzymują materiały szkoleniowe i certyfikat uczestnictwa. Istnieje również możliwość zadawania pytań prelegentowi po zakończeniu prezentacji oraz kontakt mailowy.
TERMIN: 09.06.2022, 20:00 – 21:00
CZAS TRWANIA: 1 godzin
SZKOLENIE BEZPŁATNE
CEL SZKOLENIA: Szkolenie jest realizowane w ramach cyklu webinarów Szkoły Diagnostyki Weterynaryjnej Argenta obejmujących zagadnienia z obszarów analityki ogólnej, mikrobiologii oraz cytologii weterynaryjnej wykorzystywanych w codziennej pracy lekarza klinicysty.
UCZESTNICY SZKOLENIA: szkolenie skierowane jest do lekarzy weterynarii, diagnostów laboratoryjnych, techników i osób pracujących w laboratoriach, którzy planują poszerzyć wiedzę i umiejętności dotyczące diagnostyki chorób przenoszonych przez kleszcze, w tym odpowiedniej interpretacji wyników badań.
PROGRAM SZKOLENIA:
- Aktualne wyzwania dotyczące chorób przenoszonych przez kleszcze
- Problemy diagnostyki różnicowej, czyli niejednoznaczny obraz kliniczny pacjenta
- Co oznacza diagnostyka POCT?
- Czułość i swoistość testów płytkowych
- Kiedy możemy mówić o wyniku pozytywnym?
PROWADZĄCY:
lek. wet. Ludwika Piwowarczyk, diagnosta laboratoryjny, Uniwersytet Medyczny im. K. Marcinkowskiego w Poznaniu
Mirosław Turuk, Kierownik ds. Kluczowych Klientów/ Dział Klinika - Diagnostyka Weterynaryjna, Argenta Sp. z o.o. Sp.k.
Szkolenie jest realizowane w ramach cyklu webinarów Szkoły Diagnostyki Weterynaryjnej Argenta, obejmującego zagadnienia z obszarów analityki ogólnej, mikrobiologii oraz cytologii weterynaryjnej wykorzystywanych w codziennej pracy lekarza klinicysty.
Każdy z uczestników webinariów otrzyma bezpłatny dostęp do materiałów w formie prezenatcji ppt.oraz certyfikat uczestnictwa.

Płyny z jam ciała – ważne aspekty kliniczne w codziennej praktyce weterynaryjnej - Szkoła Diagnostyki Weterynaryjnej Argenta
Szanowni Państwo,
Serdecznie zapraszamy do udziału w cyklu szkoleń internetowych- webinarów, dedykowanych specjalnie diagnostyce weterynaryjnej. Webinary to doskonały wstęp do szkoleń warsztatowych. Cykl szkoleń prowadzimy w tematyce diagnostycznej i analityki weterynaryjnej. Uczestnicy otrzymują materiały szkoleniowe i certyfikat uczestnictwa. Istnieje również możliwość zadawania pytań prelegentowi po zakończeniu prezentacji oraz kontakt mailowy.
TERMIN: 05.04.2022, 20:00 – 21:00
CZAS TRWANIA: 1 godzin
SZKOLENIE BEZPŁATNE
CEL SZKOLENIA: przedstawienie szerokiego spektrum zagadnień związanych z technikami poboru próbek, diagnostyką różnicową przesięków i wysięków, a zwłaszcza wysięki o charterze nowotworowym, omówienie procesu oceny płynów stawowych oraz mózgowo- rdzeniowych. Szkolenie jest realizowane w ramach cyklu webinarów Szkoły Diagnostyki Weterynaryjnej Argenta obejmującego zagadnienia dotyczące podstaw mikrobiologii, prawidłowego wykonywania badań w kierunku wykrywania i określania wrażliwości drobnoustrojów oraz stosowania zasad różnych technik diagnostycznych.
UCZESTNICY SZKOLENIA: szkolenie skierowane jest do lekarzy weterynarii, diagnostów laboratoryjnych, którzy w codziennej praktyce klinicznej chcą w pełni wykorzystywać badania płynów ustrojowych, w tym poprawnie interpretować wyniki.
PROWADZĄCY:
lek. wet. Ludwika Piwowarczyk, diagnosta laboratoryjny, Uniwersytet Medyczny im. K. Marcinkowskiego w Poznaniu
Mirosław Turuk, Kierownik ds. Kluczowych Klientów/ Dział Klinika - Diagnostyka Weterynaryjna, Argenta Sp. z o.o. Sp.k.
PROGRAM SZKOLENIA:
- Prawidłowe pobranie materiału do badań
- Diagnostyka różnicowa przesięków i wysięków
- Wysięki o charakterze nowotworowym
- Ocena płynu stawowego
- Ocena płynu mózgowo-rdzeniowego (PMR)
- Jakie badania należy zlecać
Szkolenie jest realizowane w ramach cyklu webinarów Szkoły Diagnostyki Weterynaryjnej Argenta, obejmującego zagadnienia z obszarów analityki ogólnej, mikrobiologii oraz cytologii weterynaryjnej wykorzystywanych w codziennej pracy lekarza klinicysty.
Każdy z uczestników webinariów otrzyma bezpłatny dostęp do materiałów w formie prezenatcji ppt.oraz certyfikat uczestnictwa.
Spotkanie naukowo-szkoleniowe Polskiego Towarzystwa Mikrobiologów Oddział w Bydgoszczy
16.00 - Powitanie oraz rozpoczęcie Zebrania - dr n. med. Alicja Sękowska Przewodnicząca PTM
Oddział w Bydgoszczy.
16.10 - 16.40 - Biofilm w zakażeniach klinicznych – w poszukiwaniu skutecznej terapii - mgr Jana Przekwas; Katedra Mikrobiologii, Collegium Medicum w Bydgoszczy Uniwersytetu Mikołaja Kopernika w Toruniu
16.40 - 17.10 - Diagnostyka zakażeń z udziałem Fusarium spp. na podstawie przypadku fungemii o etiologii
Fusarium solani - mgr Tomasz Skalski; Pracownia mykologii, Zakład Diagnostyki Mikrobiologicznej Szpital Uniwersytecki nr 2 im. dr Jana Biziela w Bydgoszczy
17.10 - 17.30 - Pełen obraz lekowrażliwości przy pierwszym badaniu - dr Andrzej Mikołajczak; Field Application Specialist, Thermo Fisher Scientific
17.30 Pytania od uczestników i zakończenie Zebrania
Za udział w szkoleniu zostaną przekazana 2 punkty edukacyjne (tzw. Punkty miękkie).

Zebranie naukowo-szkoleniowe Oddziału PTDL w Kielcach
Materiały do pobrania

Webinar / Akademia Bezpieczeństwa Żywności zaprasza Państwa do uczestnictwa w webinarium: „Co dalej po raporcie NIK nt. systemu bezpieczeństwa żywności w Polsce” (część 1)
Materiłay do pobrania

Webinar / Akademia Bezpieczeństwa Żywności zaprasza Państwa do uczestnictwa w webinarium: „Co dalej po raporcie NIK nt. systemu bezpieczeństwa żywności w Polsce” (część 2)
Materiłay do pobrania

Dziękujemy za udział w webinarze "Zebranie naukowo-szkoleniowe Oddziału PTDL w Białymstoku" - materiały do pobrania
Materiały do pobrania

Zebranie naukowo-szkoleniowe Oddziału PTDL we Wrocławiu - materiały do pobrania
Materiały do pobrania

Dziękujemy za udział w webinarze "Zebranie naukowo-szkoleniowe Oddziału PTDL w Bydgoszczy" - materiały do pobrania
Materiały do pobrania

Zebranie naukowo-szkoleniowe Oddziału PTDL w Katowicach
Szanowni Państwo, zapraszamy do udziału w zebraniach naukowo-szkoleniowych PTDL w Katowicach.
wykład "Limfocyty- obrońcy czy wrogowie"
prof. dr hab. n. med. Mirosława Pietruczuk, Uniwersytet Medyczny w Łodzi
18:50-19:10 - wykład „Nowoczesne rozwiązana hematologiczne dla każdego laboratorium”
dr n. chem./PhD. Dorota Zych-Tomkowiak, Hematology Country Project Manager, Dział Klinika, Argenta

Dziękujemy za udział w webinarze "Zebranie naukowo-szkoleniowe Oddziału PTDL w Krakowie" - materiały do pobrania
Materiały do pobrania

Dziękujemy za udział w webinarze "Zebranie naukowo-szkoleniowe Oddziału PTDL w Gdańsku" - materiały do pobrania
Szanowni Państwo, zapraszamy do udziału w zebraniach naukowo-szkoleniowych PTDL w Gdańku (09.11.2021) i Krakowie (15.11.2021). Zebranie naukowo-szkoleniowe Oddziału PTDL w Gdańsku Temat: DIMER d w diagnostyce żylnej choroby zakrzepowo-zatorowej – u kogo i jak?

Konferencja online pt. "Wypłyń na nowe rynki: Wielka Brytania"
Organizator wydarzenia Ebury.

Jak identyfikować gronkowce? Gatunki koagulazododatnie i koagulazoujemne w weterynarii
MIKROBIOLOGIA WETERYNARYJNA DLA ZAAWANSOWANYCH
PROWADZĄCY: mgr inż. Dorota Merlak – specjalista mikrobiologii, ARGENTA.
CEL SZKOLENIA: przedstawienie zagadnień związanych z budową, charakterystyką i identyfikacją gronkowców koagulazododatnich i koagulazoujemnych. Szkolenie realizowane jest w ramach cyklu: VADEMECUM KLINICYSTY – MIKROBIOLOGA obejmującego zagadnienia dotyczące podstaw mikrobiologii, prawidłowego wykonywania badań w kierunku wykrywania i określania wrażliwości drobnoustrojów oraz zasad stosowania nowoczesnych technik diagnostycznych.
UCZESTNICY: szkolenie skierowane jest do lekarzy weterynarii, diagnostów laboratoryjnych, techników i osób pracujących w laboratoriach, którzy planują rozpocząć wykonywanie badań mikrobiologicznych we własnym zakładzie leczniczym dla zwierząt lub laboratorium weterynaryjnym.
PROGRAM SZKOLENIA:
- Ogólna charakterystyka i kwalifikacja
- Budowa
- Chorobotwórczość
- Diagnostyka laboratoryjna – badanie makroskopowe, hodowla, identyfikacja
- Wybrane gronkowce koagulazododatnie w praktyce weterynaryjnej (m.in. S. aureus, S. pseudintermedius, S. intermediu, S. schleiferisubsp. cogulans, S. delphin)
- Wybrane gronkowce koaguzaloujemne w praktyce weterynaryjnej (m.in. S. epidermidis, S. haemolyticusczy, S. chromogenes, S. xylosus, S. cohnii, S. simulans, , S. devriesei, S. rostri

Akademia Bezpieczeństwa Żywności Argenty - FoodFraud
Celem Akademii Bezpieczeństwa Żywności Argenty jest przybliżenie uczestnikom zagadnień związanych z bezpieczeństwem żywności. W trakcie spotkania uczestnicy będą mieli okazję zapoznać się z tematyką związaną z fałszowaniem żywności.

Zebranie naukowo-szkoleniowe Oddziału PTDL w Bydgoszczy
Harmonogram
17:30-17:35 - przywitanie, mgr Sławomira Balcerak, Przewodnicząca Oddziału PTDL Bydgoszcz
17:35-18:05 - wykład "Choroby Rzadkie wcale nie są takie rzadkie", dr n.med. Ewa Starostecka, Konsultant wojewódzki w dziedzinie pediatrii metabolicznej, Koordynator Regionalnego Centrum Chorób Rzadkich Klinika Endokrynologii i Chorób Metabolicznych Instytutu CZMP w Łodzi
18:05-18:35 - wykład „Kompleksowe rozwiązania z zakresu immunologii i biochemii dla laboratoriów diagnostycznych”, Izabela Kopańska, Specjalista ds. Aplikacji, Dział Kliniki, Argenta
18:35-18:55 - Q&A, dr n.med. Ewa Starostecka
18:55-19:00 - zakończenie spotkania, mgr Sławomira Balcerak

Zebranie naukowo-szkoleniowe Oddziału PTDL w Lublinie
Harmonogram
17:00-17:05 przywitanie - dr n. farm. Dariusz Duma, Przewodniczący PTDL Oddział w Lublinie
17:05-17:50 wykład "Krytyczne spojrzenie na eGFR” - prof. dr hab. n. med. Krystyna Sztefko, Zakład Biochemii Klinicznej, Instytut Pediatrii, Uniwersytet Jagielloński Collegium Medicum, Kraków
17:50-18:20 wykład “Snibe Diagnostic - sprawdzone rozwiązania do diagnostyki IVD w technice CLIA.“ - Adam Nowicki, Snibe
18:20-18:40 Q&A - prof. dr hab. n. med. Krystyna Sztefko
18:40-18:50 zakończenie spotkania - dr n. farm. Dariusz Duma

Kompleksowe podejście diagnostyczne do problemu Mastitis na przykładzie praktyki Dr. Mathijs Bakker, Kierownika Laboratorium z Holandii
Szanowni Państwo,
zapraszamy do do udziału w seminarium pt. „Kompleksowe podejście diagnostyczne do problemu Mastitis na przykładzie praktyki Dr. Mathijs Bakker, Kierownika Laboratorium z Holandii”.
Agenda seminarium
- 14.00 – 14.45 - prezentacja dr. Mathijs Bakker, Kierownik laboratorium.
- 14.45 – 15.00 - „Oferta usług w zakresie diagnostyki Mastitis” - prezentacja dr n. wet. Marta Gańko, Biolab Ostróda
Wykład angielskojęzyczny tłumaczony
Udział w seminarium jest bezpłatny

Akademia Bezpieczeństwa Żywności Argenty - FoodFraud
Szanowni Państwo, zapraszamy do udziału w webinarze Akademia Bezpieczeństwa Żywności Argenty - FoodFraud (dzień 2). Celem Akademii Bezpieczeństwa Żywności Argenty jest przybliżenie uczestnikom zagadnień związanych z bezpieczeństwem żywności. W trakcie spotkania uczestnicy będą mieli okazję zapoznać się z tematyką związaną z fałszowaniem żywności.



